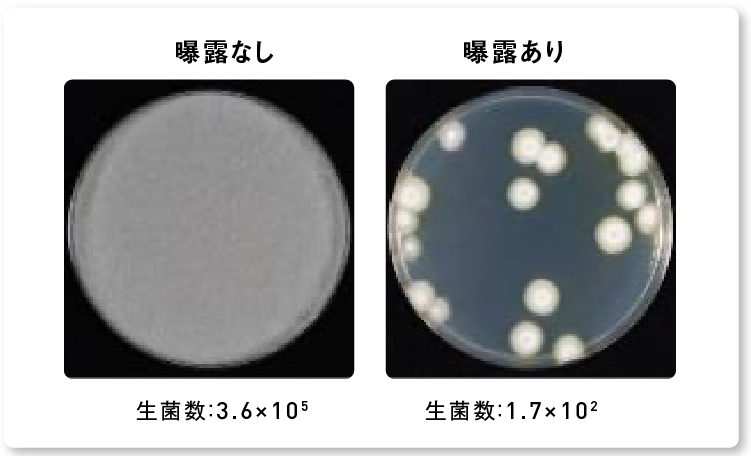
画像：ナノイー（帯電微粒子水）を4時間曝露した後のアオカビの生菌数減少の様子
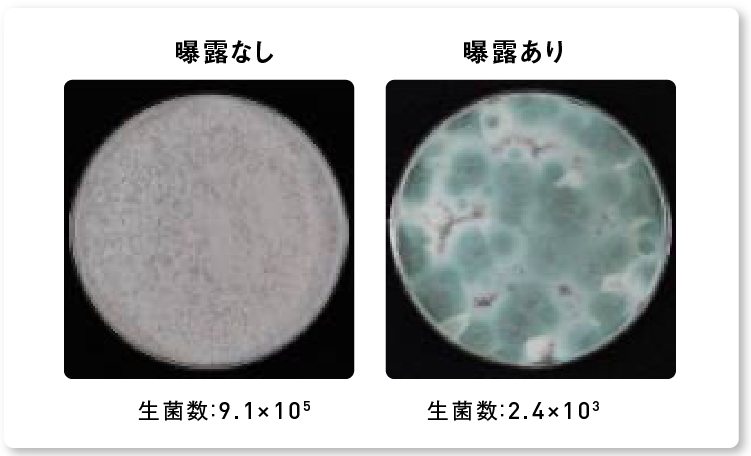
画像：ナノイー（帯電微粒子水）を8時間曝露した後のコウジカビの生菌数減少の様子
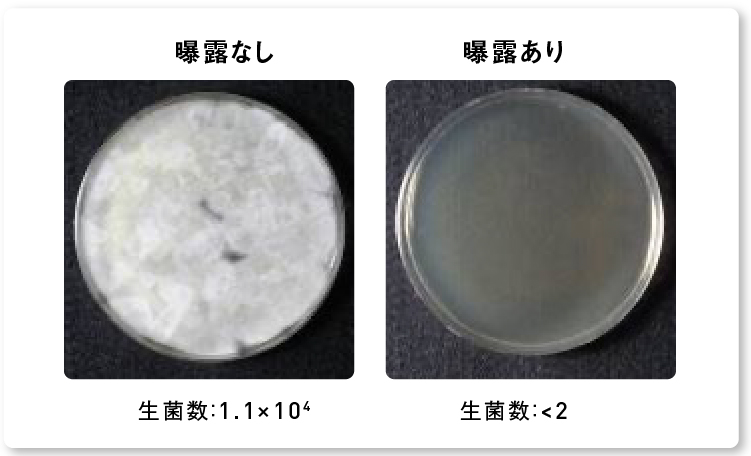
画像：ナノイー（帯電微粒子水）を8時間曝露した後のカワキコウジカビの生菌数減少の様子
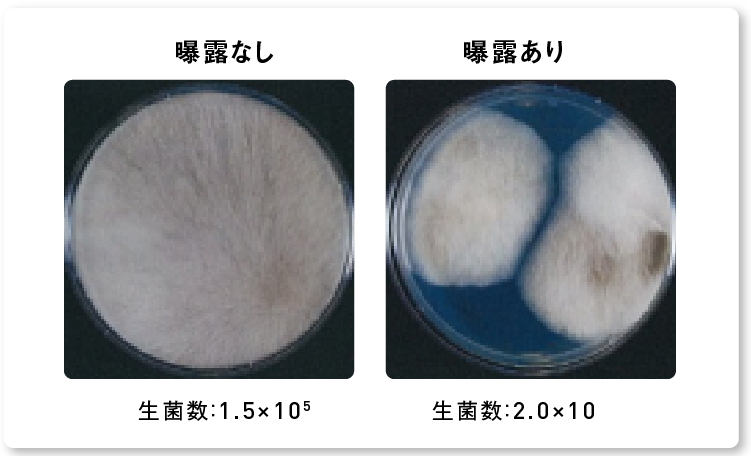
画像：ナノイー（帯電微粒子水）を8時間曝露した後のケカビの生菌数減少の様子
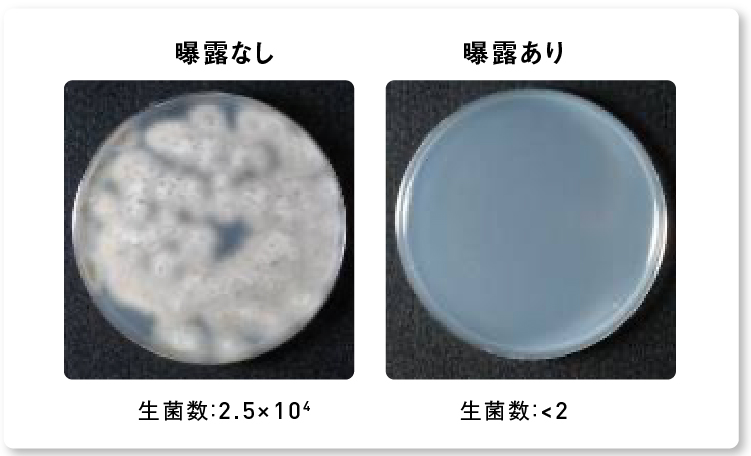
画像：ナノイー（帯電微粒子水）を8時間曝露した後の黒色カビの生菌数減少の様子

居住空間に存在するカビの成長とカビアレル物質に対して99%以上の抑制効果があることを実証!試験の結果、ナノイー(帯電微粒子水)を4~16時間照射することで家の8大カビを99%以上抑制※することが確認出来ました。
※試験は45Lの試験空間で実施され、実使用における製品の効果を実証したものではありません。
「背景」
大気中、居住空間、食品、植物、動物など、私たちの身近に広く分布してるカビ。居住空間においては風呂場などの水周りの他、ハウスダストにもカビが含まれていることが明らかになっています。
「検証結果」
家の8大カビを99%以上、カビアレル物質を93%以上抑制
4時間~16時間の曝露で、検証対象である8種のカビすべてにおいて99%以上、カビアレル物質93%以上の抑制効果を確認。ナノイー(帯電微粒子水)が家中の代表的なカビ8種類とカビアレル物質を抑制することが分かりました。
ナノイー(帯電微粒子水)を4時間曝露した後の
クロカビの抑制率
ナノイー(帯電微粒子水)を4時間曝露した後の
クロカビの生菌数減少の様子
ナノイー(帯電微粒子水)を4時間曝露した後の
アカカビの抑制率
ナノイー(帯電微粒子水)を4時間曝露した後の
アカカビの生菌数減少の様子
ナノイー(帯電微粒子水)を4時間曝露した後の
アオカビの抑制率
ナノイー(帯電微粒子水)を4時間曝露した後の
アオカビの生菌数減少の様子
ナノイー(帯電微粒子水)を8時間曝露した後の
コウジカビの抑制率
ナノイー(帯電微粒子水)を8時間曝露した後の
コウジカビの生菌数減少の様子
ナノイー(帯電微粒子水)を8時間曝露した後の
カワキコウジカビの抑制率
ナノイー(帯電微粒子水)を8時間曝露した後の
カワキコウジカビの生菌数減少の様子
ナノイー(帯電微粒子水)を8時間曝露した後の
ケカビの抑制率
ナノイー(帯電微粒子水)を8時間曝露した後の
ケカビの生菌数減少の様子
ナノイー(帯電微粒子水)を8時間曝露した後の
黒色カビの抑制率
ナノイー(帯電微粒子水)を8時間曝露した後の
黒色カビの生菌数減少の様子
ナノイー(帯電微粒子水)を16時間曝露した後の
ススカビの抑制率
ナノイー(帯電微粒子水)を16時間曝露した後の
ススカビの生菌数減少の様子
ナノイー(帯電微粒子水)を2時間曝露した後の
カビアレル物質の抑制率
[プレスリリース]
帯電微粒子水「ナノイー」(※1)のカビへの効果検証 ~ハウスダストなどに含まれるカビの成長とカビアレル物質の抑
制効果を実証~(2011年9月14日)
https://www.panasonic.com/content/dam/panasonic/jp/corporate/technology-design/nanoe/pdf_20110914_nanoe.pdf